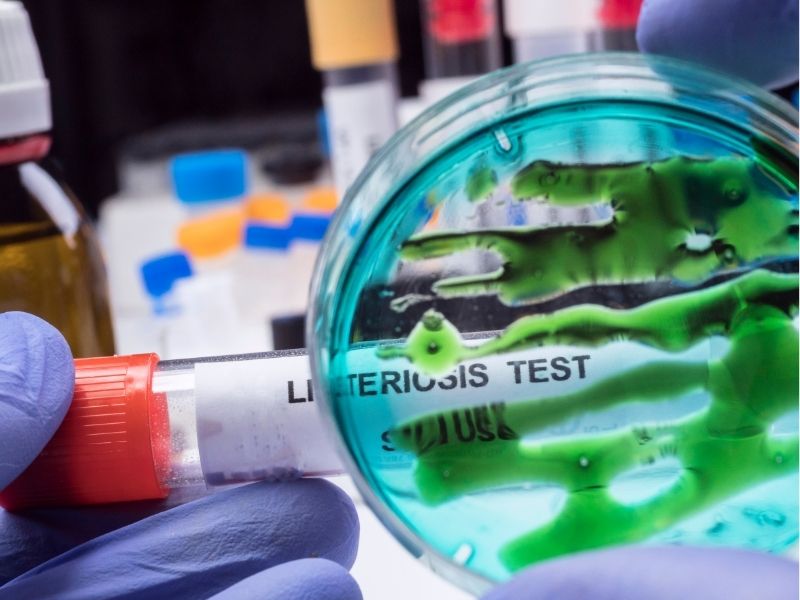

La Comisión Europea ha aprobado el Reglamento (UE) 2024/2895, que modifica el Reglamento (CE) 2073/2005 en lo que respecta a los criterios de seguridad alimentaria para Listeria monocytogenes. El Nuevo Reglamento UE 2024/2895 establece más control sobre Listeria en alimentos y refuerza las medidas para garantizar la seguridad de los productos listos para el consumo.
¿Por qué es importante este nuevo reglamento?
Esta bacteria representa un riesgo significativo para la salud pública, con una tasa de letalidad elevada y un incremento del 15,9 % en casos de listeriosis en 2022.
A partir del 1 de julio de 2026, las empresas alimentarias deberán cumplir con criterios más estrictos para garantizar que los alimentos listos para el consumo no representen un peligro para los consumidores.
Principales cambios en el Reglamento (UE) 2024/2895
🧪 Criterios de seguridad más estrictos para Listeria monocytogenes
El nuevo reglamento establece que, para los alimentos listos para el consumo que pueden favorecer el crecimiento de Listeria monocytogenes, se aplicará el siguiente criterio de seguridad:
- Si el productor no puede demostrar que Listeria monocytogenes se mantendrá por debajo del límite de 100 ufc/g durante toda la vida útil, entonces la bacteria no debe detectarse en 25 g del producto.
🏭 Mayor responsabilidad para las empresas alimentarias
Las empresas del sector deberán:
- Implementar planes de muestreo rigurosos para garantizar el cumplimiento de los nuevos límites.
- Realizar pruebas con los métodos analíticos de referencia EN/ISO 11290-1 y EN/ISO 11290-2.
- Ajustar sus procedimientos antes del 1 de julio de 2026, fecha en que la normativa será de obligado cumplimiento.
🛒 Repercusiones en la producción y comercialización de alimentos
Estos cambios afectarán a toda la cadena de producción y distribución de alimentos listos para el consumo, en especial aquellos que pueden favorecer el crecimiento de Listeria monocytogenes, excluyendo los destinados a lactantes o usos médicos especiales.
Los productores deberán demostrar ante las autoridades que el alimento permanecerá dentro del límite de 100 ufc/g durante su vida útil, o de lo contrario, será obligatorio garantizar la ausencia total en 25 g del producto.
Consejos para cumplir con el nuevo reglamento
Si eres parte del sector alimentario, es clave prepararse para estos cambios. Aquí tienes algunas recomendaciones:
🔍 Revisión de procesos y planes APPCC
- Actualiza el Análisis de Peligros y Puntos Críticos de Control (APPCC) para incluir medidas más estrictas contra Listeria monocytogenes.
- Refuerza las buenas prácticas de higiene en toda la cadena de producción y distribución.
🧫 Implementación de controles microbiológicos
- Realiza pruebas periódicas en productos listos para el consumo con los métodos EN/ISO indicados en la norma.
- Verifica que la concentración de Listeria monocytogenes no supere los 100 ufc/g en ningún momento de la vida útil.
📆 Planificación anticipada para el cumplimiento normativo
- Ajusta los protocolos internos antes de julio de 2026 para evitar sanciones o la retirada de productos del mercado.
- Forma a los equipos de producción y calidad en los nuevos requisitos de seguridad alimentaria.
Impacto en el sector alimentario y la seguridad del consumidor
Con estas medidas, la UE busca reducir los casos de listeriosis y proteger a los consumidores más vulnerables. Aunque la normativa supone nuevos desafíos para la industria, también refuerza la confianza del consumidor en la seguridad de los alimentos listos para el consumo.
Conclusión: ¡Actúa ahora para cumplir con la nueva normativa! 📢
El Reglamento (UE) 2024/2895 representa un paso importante para mejorar la seguridad alimentaria en la UE. Todas las empresas del sector deben adaptarse antes de julio de 2026 para cumplir con los nuevos requisitos.
Si necesitas asesoramiento sobre cómo implementar estos cambios en tu empresa, contáctanos y te ayudaremos a garantizar el cumplimiento normativo. En RQR Consultoría, contamos con una amplia experiencia asesorando a empresas del sector alimentario en la implementación y cumplimiento de normativas europeas de seguridad e higiene.
📌 ¿Te interesa estar al día con los cambios en la legislación alimentaria? Visita nuestra sección de blog especializada en normativas del sector 👉 Legislación Alimentaria en RQR Consultoría